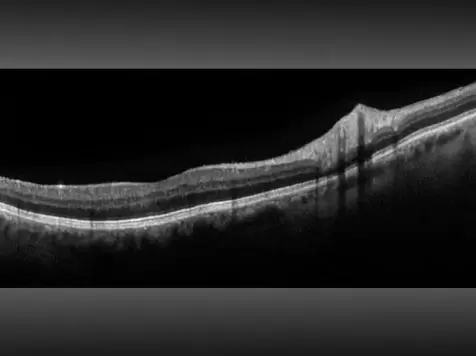
Picture

Our Services
Comprehensive Vision & Eye Health Examinations
Retina Imaging/ Optos Monaco with OCT
Contact Lens Examinations/ Fittings/ Orders
Soft Contact Lenses
Soft Toric/ Astigmatism Contact Lenses
Multifocal Contact Lenses
Monovision Contact Lenses
Rigid Gas Permeable Contact Lenses
Scleral Rigid Gas Permeable Lenses
Hybrid Contact Lenses
Keratoconus Specialty Contact Lenses
Medically Necessary Contact Lenses
Dry Eye Treatment
Plunctal Plugs for Dry Eyes
NuLids Pro Eyelid Cleaning
Designer Frame Gallery
Wide Selection and Variety Frames
In Office Finishing/ Edging Lab
Fill Outside Prescriptions
Refractive Surgery / LASIK Consultations
Stellest Lenses for Myopia Control
MiSight Myopia Management Program
Orthokeratoly (Ortho-K) Contact Lens Program
Low Dose Atropine Myopia Management Program
|
| ||||||||||||
Facilities and Equipment
Computerized autorefraction and automated phoropters
Computerized automated visual field analysis
Optomap retina imaging
OCT= Optical Coherence Tomography: uses light waves to take cross-section images of the retina, macula, optic nerve.
ICare200, no air puff tonometer, available
Wide variety of frames
Spacious approximately 4500 sq ft office
2 pretesting rooms to reduce patient wait time
Beverage bar
Wheelchair friendly office
Baby changing table station
Convenient free parking in front and side of building
Centrally located by multiple cities, easy access from 215 and 60 Fwy

Optos Monaco combines optomap ultra-widefield technology with SD-OCT creating a fast, convenient, multi-modal imaging tool. Monaco can produce a 200°, single-capture retinal images of unrivaled clarity and can display a six-image overview including color, AF, and OCT of both eyes in as little as 90 seconds.
Insurance Plans Accepted
We accept Vision Service Plan (VSP), EyeMed, and Loma Linda Risk Management. Please feel free to ask us if you have any questions regarding your insurance.
Insurance Plans Accepted
We accept Vision Service Plan (VSP), EyeMed, and Loma Linda Risk Management. Please feel free to ask us if you have any questions regarding your insurance.
Types of Payment Accepted
We accept Cash, Master Card, Visa, Discover, American Express, Debit, Apple Pay and Care Credit. We do not accept personal checks.
Appointment Cancellation Policy
Please cancel or reschedule your appointment with a 24 hour notice so we do not have to charge $50 for the held appointment time, that defers more urgent eyecare needs.
Eyewear and Prescription Policy
We recommend you choose your eyewear carefully. Due to custom orders with eyeglasses and contact lenses, we are unable to accept a change of mind return, general returns which includes plano sunglasses, or exchanges. We also do not accept cancellations and modifications on optical orders once an order is placed since they are custom made.
Types of Payment Accepted
We accept Cash, Master Card, Visa, Discover, American Express, Debit, Apple Pay and Care Credit. We do not accept personal checks.
Appointment Cancellation Policy
Please cancel or reschedule your appointment with a 24 hour notice so we do not have to charge $50 for the held appointment time, that defers more urgent eyecare needs.
Eyewear and Prescription Policy
We recommend you choose your eyewear carefully. Due to custom orders with eyeglasses and contact lenses, we are unable to accept a change of mind return, general returns which includes plano sunglasses, or exchanges. We also do not accept cancellations and modifications on optical orders once an order is placed since they are custom made.
Languages Spoken
Our staff speaks Spanish, Vietnamese, and Mandarin.